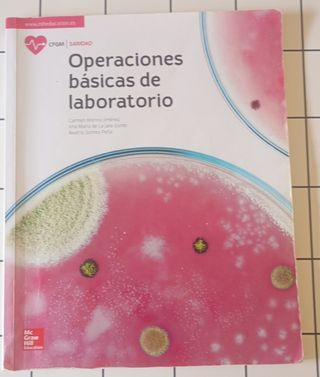

Libros Grado Medio de segunda mano Donostia-San Sebastián
Novedades
Libro Promoción de la SALUD
Libro de Grado Medio para materias de estudios de farmacia y parafarmacia
Libro Operaciónes Básicas De Laboratorio
Libro en buen estado de grado medio libro para la laboratorio para estudios de Farmacia..
Libro Empresa e iniciativa emprendedora
Libro de grado medio de la materia de empresa en excelente estado...
Empresa e Iniciativa emprendedora (3 Libros FP)
Empresa e Iniciativa emprendedora Santillana Formacion Profesional: Grado Medio y Grado Superior. Empresa e Iniciativa Emprendedora Mc Graw Hill Education. Se venden tres libros como nuevos, sin subrayar. Los tres 25€ Se pueden vender por separado (10€ cada uno)
Operaciones auxiliares de gestión de tesorería
Libro de tesorería, FP grado medio en buen estado, por dentro está muy conservado. En castellano. Precio original 34€ Realizo el envío en el mismo día, si compras antes del mediodía. 🔸Ligeras marcaciones en algunas páginas, pero son menos de 10, son en lápiz o resaltador. 🔸Está muy cuidado, ver fotos❗️ No dudes en consultar✨ 💯 Visita mi perfil para ver más libros de texto y literatura 💯 #libros #texto #gradomedio #administracion #fp #fpsuperior #fpmedio #estudio #biblioteca #instituto #formacion #fol #cfgm #tesoreria #barato
Formación y Orientación Laboral
Libro para grado medio de Formación y orientación laboral..
Technical English 2nd Edition Level 1 Course Bo...
Libro de inglés grado medio, estado aceptable tiene alguna página escrita. Forrado
Formació I orientació laboral
Libro Para Grado Medio Formació i Orientacio Laboral
Encuentra lo que buscas en Wallapop:
También puede interesarte
Libros Grado Medio cocina
Libros Grado Medio Auxiliar farmacia
Libros Grado Medio automoción
Libros Grado Medio estética
Libros Uned
Libros Harry Potter
Libros Don Quijote de la Mancha
Libros Disney
Libros El Lazarillo de Tormes
Libros infantiles
Libros diario de Greg
Libros inglés
Libros religiosos
Libros La voz de tu alma
Libros Stephen King
Libros Geronimo Stilton